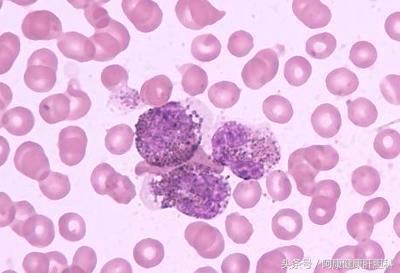
慢粒不转阴意味有复发危险吗,慢粒治疗不理想只能换药吗

慢性粒细胞白血病分为三期,一是慢性期,二是加速期,三是急变期,针对此病未接受治疗的中位生存期,约为3.1年。
「慢性期」
临床表现多无症状或有低热、乏力、多汗、体重减轻等症状。
「加速期」
病人一般有不明原因的发热、贫血、出血加重和或骨骼疼痛,有的会出现脾脏进行性肿大。
「急变期」
慢粒临床病症较为严重明显,原始细胞(Ⅰ型+Ⅱ型)或原淋+幼淋,或原单+幼单在外周血或骨髓中>=20%, 外周血中原始粒+早幼粒细胞>=30%。有髓外原始细胞浸润,骨髓中原始粒+早幼粒细胞>=50%。
慢粒不再被认为是不可治愈的白血病
以前人们常常谈白血病色变,然而,时至今日,白血病不再让人如此生畏。只要在医生的正确指导下服用靶向药物,患者就可以回归社会,回归生活,回归家庭。
2000年后,尤其是TKI靶向药物问世后,绝大多数慢粒患者都接受了伊马替尼等靶向药物治疗,临床疗效非常好,慢粒治疗得到了一个很大的飞跃,慢粒患者完全可以和正常人一样生活、工作。

规范化服药是保证疗效的关键
规范化地服用TKI药物是保证疗效的关键,患者不可随意停药或自行减量。随意减量或停药可能是由于患者出现了不良反应或经济负担较重等主观及客观因素,随意减量或停药会导致血药浓度降落,不能很好地控制白血病干细胞的恶性克隆性增殖。因此,我们倡导患者一定要在有慢粒治疗经验的血液科医师的指导下,合理规范地使用TKI。对患者进行充分的宣教非常必要,由于患者对药物不了解,到了维持阶段,认为自己已经治疗得很好了,为了省钱,只吃一半的剂量,这样很容易导致疾病复发。

慢粒患者是否需要终生服药?
目前国内外都在进行有关停药的尝试。由于停药后的复发率到底如何尚不可知,因此停药要慎重。
慢粒白血病患者在临床上治疗上,无论化疗还是口服靶向药物,初次治疗的效果大多显著,症状、体征可完全消失,血象、骨髓象恢复正常或接近正常,在发生急变之前,体力的恢复和一般健康情况往往都很好。因此积极开展治疗是关键。